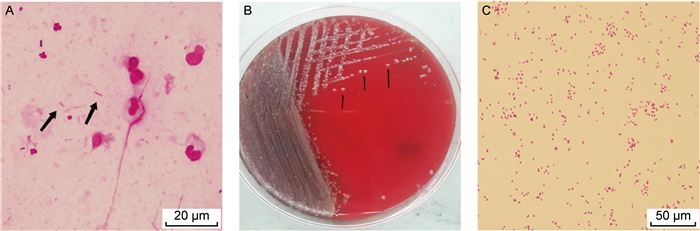

2. 同济大学附属东方医院检验科,上海 200123
2. Department of Laboratory Medicine, East Hospital Affiliated To Tongji University, Shanghai 200123, China
脲放线杆菌(Actinobacillus ureae)属于巴斯德菌科,又称脲巴斯德氏菌,是一种罕见的革兰氏阴性杆菌[1]。1986年,Mutters及其同事[2]提出了一种基于DNA-DNA杂交技术,将脲巴斯德菌(Pasteurella ureae)转移到放线杆菌属(Actinobacillus),命名为脲放线杆菌。放线杆菌是HACEK组的成员之一,此类苛养菌是指在人类口腔、呼吸道以及泌尿生殖道中存在的正常菌群。大多数放线杆菌属存在于动物中,只有人放线杆菌和脲放线杆菌是人类口咽、上呼吸道或下呼吸道的菌群。在特定条件下,这些细菌可引起严重的机会性感染。可从有基础疾病患者的上呼吸道或下呼吸道标本中分离出来[3-4],且脲放线杆菌在一些脑膜炎[5-7]和关节炎[8-9]患者标本中也可被检出。这类患者普遍存在高血压、糖尿病和恶性肿瘤等基础疾病和酗酒等不良生活习惯。本病例是肺部恶性肿瘤患者经过化疗后由脲放线杆菌引起的肺部感染,且该患者存在糖尿病、高血压和肺恶性肿瘤等易感因素。通过基质辅助激光解吸飞行时间质谱仪(matrix-assisted laser desorption ionization-time of flight mass spectrometer, MALDI-TOF MS)鉴定和16S rRNA测序分析确定该病原体为脲放线杆菌(A. ureae),并参考2015年美国临床实验室标准化协会(Clinical & Laboratory Standards Institute, CLSI)M45-A3标准对该菌进行药敏试验,为临床治疗提供依据。
1 临床材料 1.1 病例患者男性,65岁,在体检中发现肺占位性病变,被确诊为肺恶性肿瘤后自行服用中药至今情况未好转。入院前患者出现咳嗽、咳白色黏痰,无胸闷、气促、发热等症状,为求进一步治疗入院。患者既往糖尿病史20年余,使用胰岛素控制血糖;高血压病史50年余,平素服用氯沙坦钾片控制血压。并且有30年吸烟史以及40年饮酒史。
入院时查体:体温36.5 ℃,血压:132/82 mmHg,言语流利,神志清楚,颈静脉充盈正常,颈动脉搏动正常。心率:80次/分,心律齐,心音有力,各瓣膜听诊区未闻及病理性杂音,未闻及心包摩擦音。
1.2 检查结果 1.2.1 实验室检查入院辅助检查显示:白细胞计数10.51×109/L,中性粒细胞计数6.82×109/L,超敏C反应蛋白11.07 mg/L,血清淀粉样蛋白17.04 mg/L。胸部计算机断层扫描术(computer tomography,CT)结果如图 1所示,患者右上肺门肺癌伴右肺门及纵隔淋巴结转移,右侧胸腔积液,右肺部分膨胀不全,双肺多发转移瘤,胸骨及胸椎转移,双侧锁骨上淋巴结转移。初步诊断为肺恶性肿瘤并伴有肝、骨、淋巴结、胸膜转移。

|
| 图 1 患者入院时胸部CT征象 Fig. 1 Chest CT signs on patient admission |
住院第3天行胸部正位CT检查,显示右上纵隔增宽,两肺纹理增多,弥漫分布小结节,右肺中下肺野有致密影。为患者进行右侧胸腔积液引流,胸腔引流操作成功,患者无胸闷、大汗等不适后返回病房。胸腔积液送至检验科进行常规和生化检查:常规结果显示有核细胞计数393×106/L,中性粒细胞占26%,淋巴细胞占62%;生化检测结果显示葡萄糖8.87 mmol/L,总蛋白42 g/L,乳酸脱氢酶173 IU/L,氯93 mmol/L,腺苷酸脱氨酶5.0 U/L,患者各项结果提示无化疗绝对禁忌证。入院第4天排除相关禁忌证后开始抗肿瘤治疗,治疗后无化疗相关不良反应。
入院第7天患者出现胸痛、咳嗽、咳痰加重,体温升高至38.2 ℃。实验室检查显示白细胞计数4.72×109/L,降钙素原1.24 ng/mL,白介素6 169 pg/mL,可溶性生长刺激表达基因蛋白为2 130.4 ng/ml。临床考虑化疗后免疫功能下降引起的肺部感染。
1.2.2 微生物检查入院第7天留取痰液标本送至检验科微生物室进行培养,标本性状为白色黏痰,革兰氏染色后镜下可见大量白细胞和革兰氏阴性杆菌(见图 2A)。将痰标本接种于血琼脂平板培养基、麦康凯琼脂培养基及含万古霉素的巧克力琼脂培养基,置于35 ℃、5% CO2培养箱培养,24 h后观察血琼脂平板培养基菌落形态为灰白色、湿润、不溶血、稍凸起、边缘光滑整齐的菌落(见图 2B),革兰氏染色为革兰氏阴性杆菌(见图 2C)。经基质辅助激光解吸电离飞行时间质谱仪(中元汇吉生物技术有限公司,中国)分析,鉴定为脲放线杆菌(见图 3),通过16S rRNA测序比对确认该菌株为脲放线杆菌。由于该菌生长优势明显,结合患者化疗后因免疫功能低下出现的发热、咳嗽和咳痰等临床表现,临床认为该病原体为致病菌的可能性较大。
|
|
A: Gram-stained results of sputum smear under oil immersion lens (1000×) (indicated by black arrows); B: Actinobacillus ureae colonies cultured for 24 h at 35 ℃ CO2 on blood agar plates (indicated by black arrows); C: Gram-stained results of single colony smear under oil immersion lens (1000×). 图 2 脲放线杆菌的形态学特征 Fig. 2 Morphological characterization of Actinobacillus ureae |

|
| 图 3 脲放线杆菌分离株质谱蛋白峰图 Fig. 3 Mass spectrometry protein peak profile of Actinobacillus ureae isolates |
由于脲放线杆菌较少检出,临床实验室一般不常规开展药敏试验。因此,本研究参照CLSI M45-A3 HACEK菌群药敏试验方法进行药物敏感性试验,结果为左氧氟沙星≤0.12 μg/mL,头孢哌酮舒巴坦≤8 μg/mL,亚胺培南≤0.25 μg/mL,美罗培南≤0.25 μg/mL,复方新诺明≤20 μg/mL。及时向临床医师反馈药敏结果,使用头孢哌酮舒巴坦联合左氧氟沙星静脉滴注抗感染治疗。经治疗后患者体温逐渐恢复正常,实验室检测白细胞计数5.75×109/L、中性粒细胞计数2.86×109/L,炎性指标恢复正常。患者病情稳定,治疗过程无并发症,肺部炎症恢复良好。
2 讨论放线杆菌属(Actinobacillus)是一类兼性厌氧、无动力的革兰氏阴性杆菌,其中包括感染动物的放线杆菌,如马驹放线杆菌、李氏放线杆菌和猪放线杆菌等;仅感染人的放线杆菌,如脲放线杆菌和人放线杆菌等。脲放线杆菌通常为口腔正常菌群,国内已有报道在免疫功能低下时可引起肺部机会性感染[3-4, 10]。脲放线杆菌可引起菌血症[11-12]、脑膜炎[13-14]、心内膜炎[15-16]、肺炎[17]和伤口感染[18]等疾病。在这些患者中,标本多来自无菌体液如脑脊液和血液,临床病程普遍出现发热症状。与本病例肺部感染出现发热表现一致。然而,对于结膜炎[19]和中耳炎[20]的患者,文献中并未提及发热情况,提示发热可能与感染的侵袭程度或宿主炎症反应强度有关。这提示在临床实践中须了解不同患者的基础疾病及易感风险,及时采取有效的诊治措施。
在恶性肿瘤患者感染后期,住院期间较易发生机会性细菌肺部感染。这是由于多次手术、放化疗和抗菌药物治疗导致此类患者机体免疫功能低下,上呼吸道定植菌转变为机会性致病菌,或诱导细菌从原型转变为L型[21]。目前脲放线杆菌尚未发现其具有很强的致病性,但对于免疫功能低下且有基础疾病的患者,可在体内大量繁殖,导致局部感染。由于脲放线杆菌是口腔和呼吸道的正常定植菌,当脲放线杆菌引起肺部感染时,实验室人员往往会忽略其致病性,造成错误判断而漏检,延迟临床诊断。因此,早期发现后及时与临床沟通,指导其合理使用抗菌药物使患者取得良好治疗效果。
目前,脲放线杆菌引起的感染病例报道较少。根据现有文献学习,发现这些病例中患者的共同点包括糖尿病、高血压和恶性肿瘤等基础疾病和长期酗酒、吸烟等不良生活习惯。因此,恶性肿瘤、慢性酒精中毒、颅骨损伤、手术后以及免疫功能低下的患者更容易感染脲放线杆菌。在脲放线杆菌所致的呼吸道感染病例中,具有慢性肺病史或肺部基础疾病的患者感染脲放线杆菌的风险明显增加。
综上所述,在临床诊疗过程中,须特别关注具有恶性肿瘤等基础疾病或免疫功能低下的患者,提高实验室工作人员对少见菌的识别、处理能力和与临床沟通能力,为及时诊治少见菌引起的机会性感染提供依据。
| [1] |
Bercovier H, Escande F, Grimont PA. Biological characterization of Actinobacillus species and Pasteurella ureae[J]. Ann Microbiol (Paris), 1984, 135A(2): 203-218.
[PubMed]
|
| [2] |
Mutters R, Pohl S, Mannheim W. Transfer of Pasteurella ureae Jones 1962 to the Genus Actinobacillus Brumpt 1910: Actinobacillus ureae comb. Nov[J]. Int J Syst Bacteriol, 1986, 36(2): 343-344.
|
| [3] |
Yang Q, Zhong Q, Wu B, Xu X, Li W, Zhao B, Luo M, Zhu X, Ye D, Huang Y. Actinobacillus ureae may be a critical pathogen in patients with predispositions: a case report and review of the literature[J]. Medicine (Baltimore), 2023, 102(46): e36087.
[DOI]
|
| [4] |
陈雪梅, 丁声龙, 陈远洋, 周全红. 宏基因组学新一代测序技术诊断尿放线杆菌肺炎一例[J]. 中华肺部疾病杂志, 2022, 15(5): 765-767. |
| [5] |
杨亚敏, 张富玉, 阚志超, 龙莉, 陈毅丽. 尿放线杆菌致化脓性脑膜炎一例[J]. 天津医药, 2009, 37(12): 1010-1010. |
| [6] |
de Castro N, Pavie J, Lagrange-Xélot M, Bouvry D, Delisle F, Parrot A, Molina JM. Severe Actinobacillus ureae meningitis in an immunocompromised patient: report of one case and review of the literature[J]. Scand J Infect Dis, 2007, 39(11/12): 1076-1079.
[PubMed]
|
| [7] |
Kaka S, Lunz R, Klugman KP. Actinobacillus (Pasteurella) ureae meningitis in a HIV-positive patient[J]. Diagn Microbiol Infect Dis, 1994, 20(2): 105-107.
[PubMed]
|
| [8] |
Kaur PP, Derk CT, Chatterji M, Dehoratius RJ. Septic arthritis caused by Actinobacillus ureae in a patient with rheumatoid arthritis receiving anti-tumor necrosis factor-alpha therapy[J]. J Rheumatol, 2004, 31(8): 1663-1665.
[PubMed]
|
| [9] |
Avlami A, Papalambrou C, Tzivra M, Dounis E, Kordossis T. Bone marrow infection caused by Actinobacillus ureae in a rheumatoid arthritis patient[J]. J Infect, 1997, 35(3): 298-299.
[PubMed]
|
| [10] |
熊章华, 孙敬, 汤学夫, 余理智, 邓林. 尿放线杆菌引起呼吸道感染一例[J]. 江西医学检验, 2001, 19(2): 120-120. |
| [11] |
Lee WC, Yoon HJ. The first case of psoas muscle abscess and sepsis caused by Actinobacillus ureae in a chronic hepatitis B patient in Korea[J]. Infect Chemother, 2009, 41(2): 95-98.
|
| [12] |
Verhaegen J, Verbraeken H, Cabuy A, Vandeven J, Vandepitte J. Actinobacillus (formerly Pasteurella) ureae meningitis and bacteraemia: report of a case and review of the literature[J]. J Infect, 1988, 17(3): 249-253.
[PubMed]
|
| [13] |
Kingsland RC, Guss DA. Actinobacillus ureae meningitis: case report and review of the literature[J]. J Emerg Med, 1995, 13(5): 623-627.
[PubMed]
|
| [14] |
Whitelaw AC, Shankland IM, Elisha BG. Use of 16S rRNA sequencing for identification of Actinobacillus ureae isolated from a cerebrospinal fluid sample[J]. J Clin Microbiol, 2002, 40(2): 666-668.
[PubMed]
|
| [15] |
徐祖才, 罗鑫, 张骏, 徐忠祥. 重症尿素放线杆菌感染性心内膜炎合并脑栓塞1例报告[J]. 临床神经病学杂志, 2016, 29(4): 258-258. |
| [16] |
赵琼琼, 柳茵. 尿放线杆菌致感染性心内膜炎一例[J]. 中国医药, 2011, 06(12): 1563-1563. |
| [17] |
Dawar R, Nagarjuna D, Gupta R, Ghonge NP, Sardana R. Actinobacillus ureae: an unusual cause of tree-in-bud pattern in a case of pneumonia on lung computed tomographic scan-first clinical case report and review of the literature from India[J]. New Microbes New Infect, 2016, 14: 69-72.
[PubMed]
|
| [18] |
Noble RC, Marek BJ, Overman SB. Spontaneous bacterial peritonitis caused by Pasteurella ureae[J]. J Clin Microbiol, 1987, 25(2): 442-444.
[PubMed]
|
| [19] |
Ergin C, Kaleli I, Kiliç I. Acute conjunctivitis caused by Actinobacillus ureae[J]. Pediatr Int, 2007, 49(3): 412-413.
[PubMed]
|
| [20] |
Bigel ML, Berardi-Grassias LD, Furioli J. Isolation of Actinobacillus ureae (Pasteurella ureae) from a patient with otitis media[J]. Eur J Clin Microbiol Infect Dis, 1988, 7(2): 206-207.
[PubMed]
|
| [21] |
杨占军, 许青霞, 邵国庆, 王传兵. 恶性肿瘤患者肺部感染细菌L型变异的检测报告[J]. 检验医学, 2005, 20(1): 19-22. |
 2025, Vol. 20
2025, Vol. 20


